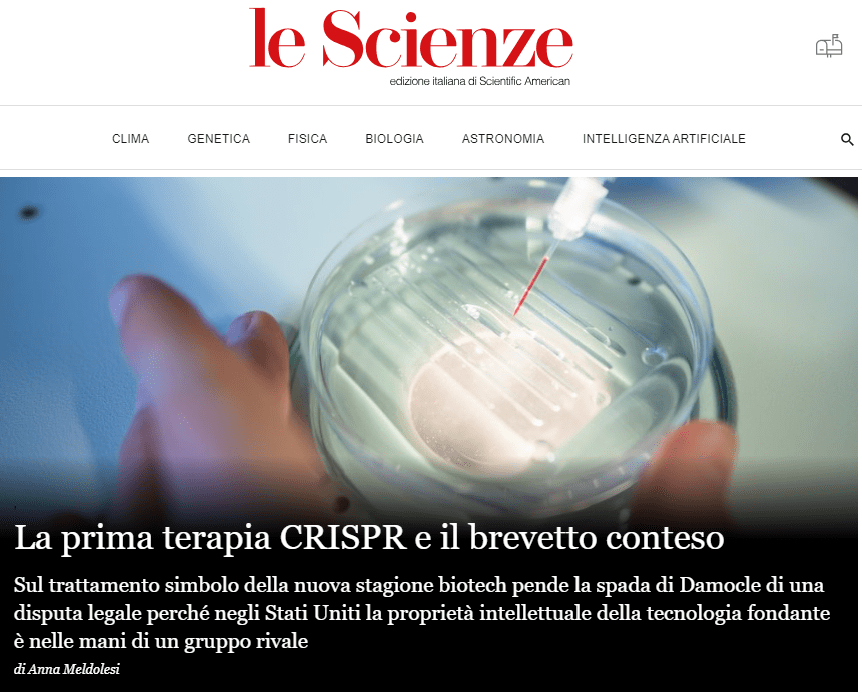

Lunedì 13 maggio, di prima mattina, Vittoria Brambilla aprirà il suo scrigno tecnologico presso il Dipartimento di scienze agrarie e ambientali dell’Università di Milano. In gergo si chiama fitotrone ed è una cella climatizzata. Qui sono custodite 400 preziose piantine, pronte per essere trasferite nel primo campo sperimentale italiano dell’era CRISPR, con la benedizione del Ministero dell’ambiente e della sicurezza energetica. Le aspetta un terreno fertile in cui affondare le delicate radici, e poi sole, vento, pioggia e forse siccità e parassiti. Tutto ciò che di mutevole accade quando si cresce all’aperto, anziché dentro a un laboratorio”. Per sapere tutto di questo debutto in campo (il primo dopo 20 anni di attesa in Italia), della sperimentazione che sta per iniziare e di chi l’ha resa possibile, c’è il mio nuovo pezzo per Le Scienze, con commenti di Vittoria Brambilla, Roberto Defez, Elena Cattaneo, Roberto Schmid e Federico Radice Fossati, l’imprenditore che ha offerto il suo terreno per la sperimentazione. Per maggiori dettagli tecnici su questo riso resistente a un fungo (il brusone) c’è l’anticipazione che avevo pubblicato su Nature Italy. Nella gallery qui sopra invece trovate: ricercatori e ricercatrici dei laboratori diretti da Vittoria Brambilla e Fabio Fornara a cui si deve questo passo in avanti, l’insegna affissa fuori dal campo sperimentale, la cella climatizzata che fino a lunedì 13 maggio custodirà le piantine editate, uno dei vassoi in cui saranno trasportate, la gabbia che delimita il campo sperimentale, ancora da completare con la parte superiore (28 mq a Mezzana Bigli, in provincia di Pavia). Buona sperimentazione!